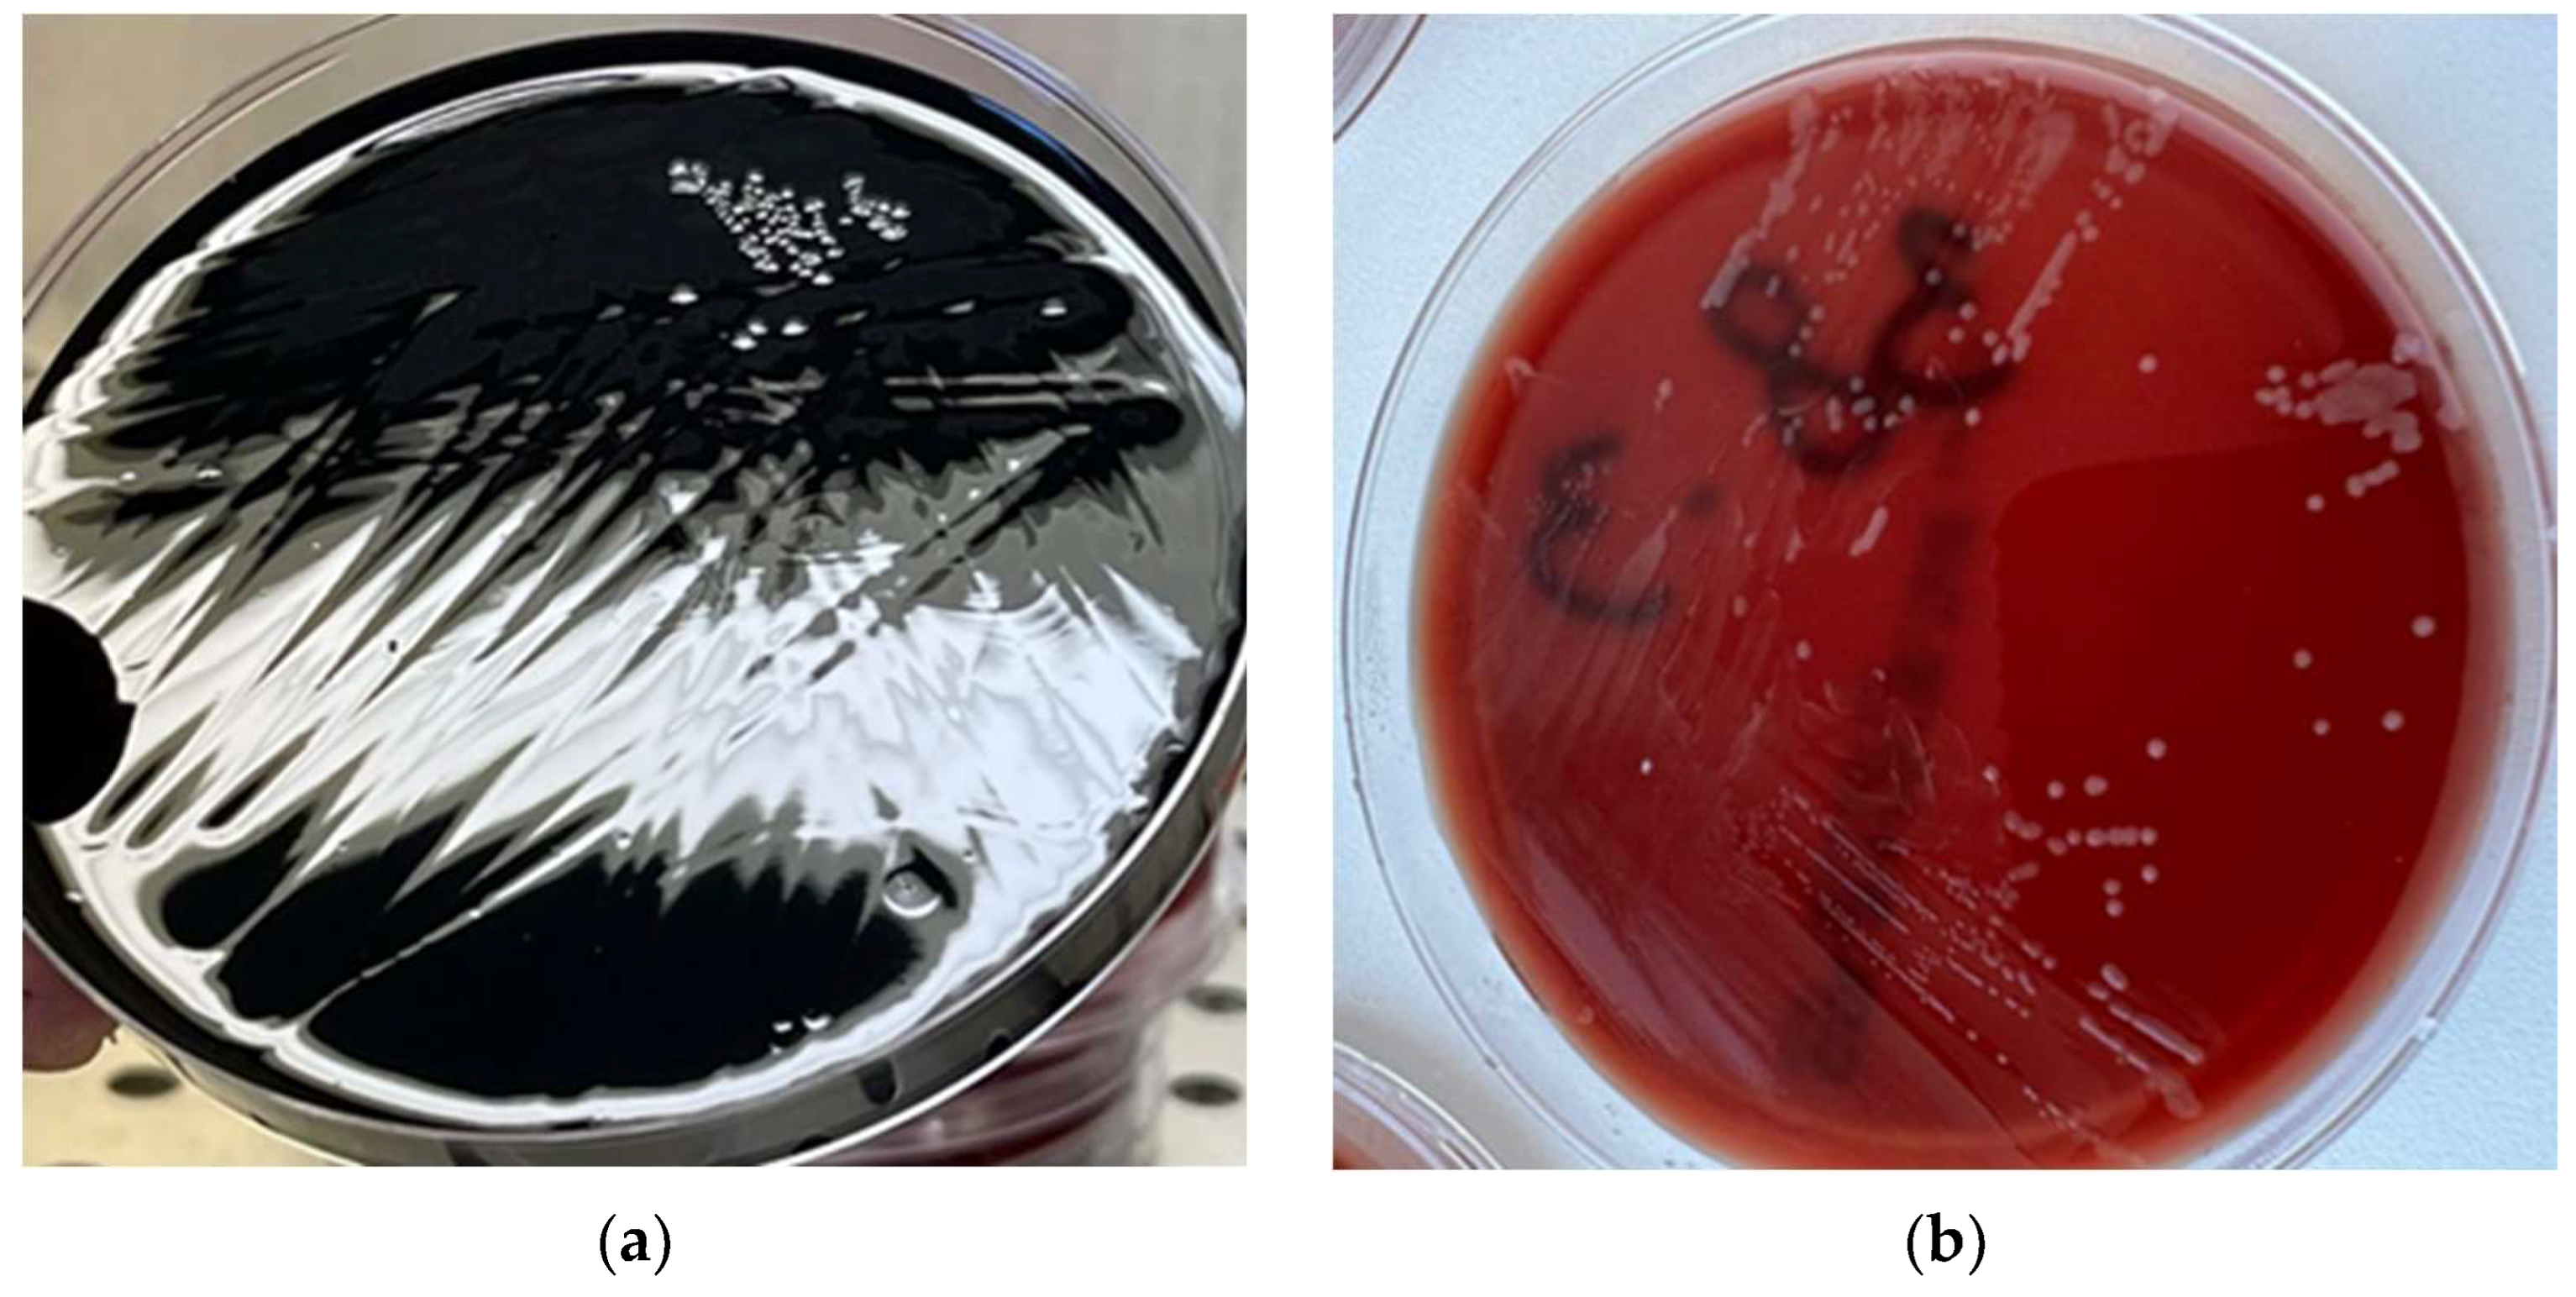
Pathogens 14 00316 g001

Public Health Risk of Campylobacter spp. Isolated from Slaughterhouse and Retail Poultry Meat: Prevalence and Antimicrobial Resistance Profiles
Abstract
:1. Introduction
2. Materials and Methods
2.1. Sample Collection
2.2. Isolation and Identification of Campylobacter spp.
2.3. Antimicrobial Susceptibility Tests
2.4. Statystical Analyses
3. Results
3.1. Campylobacter spp. Prevalence
3.2. Antimicrobial Susceptibility Test Results
4. Discussion
5. Conclusions
Author Contributions
Funding
Institutional Review Board Statement
Informed Consent Statement
Data Availability Statement
Conflicts of Interest
References
- Gržinić, G.; Piotrowicz-Cieślak, A.; Klimkowicz-Pawlas, A.; Górny, R.L.; Ławniczek-Wałczyk, A.; Piechowicz, L.; Olkowska, E.; Potrykus, M.; Tankiewicz, M.; Krupka, M.; et al. Intensive Poultry Farming: A Review of the Impact on the Environment and Human Health. Sci. Total Environ. 2023, 858, 160014. [Google Scholar] [CrossRef]
- Food and Agriculture Organization of the United Nations (FAO). Meat Market Review: Emerging Trends and Outlook. Available online: https://openknowledge.fao.org/items/9e01dd92-9217-47e8-8134-90a8955e30c0 (accessed on 5 December 2024).
- European Commission. EU Agricultural Outlook for Markets, Income and Environment 2021–2031; Publications Office of the European Union: Brussels, Belgium, 2021; pp. 1–83. [Google Scholar]
- Wahyono, N.D.; Utami, M.M.D. A Review of the Poultry Meat Production Industry for Food Safety in Indonesia. J. Phys. Conf. Ser. 2018, 953, 12125. [Google Scholar] [CrossRef]
- Connolly, G.; Campbell, W.W. Poultry Consumption and Human Cardiometabolic Health-Related Outcomes: A Narrative Review. Nutrients 2023, 15, 3550. [Google Scholar] [CrossRef] [PubMed]
- Fletcher, D.L. Poultry meat quality. World’s Poult. Sci. J. 2002, 58, 131–145. [Google Scholar] [CrossRef]
- Petracci, M.; Cavani, C. Muscle growth and poultry meat quality issues. Nutrients 2012, 4, 1–12. [Google Scholar] [CrossRef]
- European Food Safety Authority (EFSA); European Centre for Disease Prevention and Control (ECDC). The European Union One Health 2023 Zoonoses report. EFSA J. 2024, 22, e9106. [Google Scholar] [CrossRef]
- Antunes, P.; Mourão, J.; Campos, J.; Peixe, L. Salmonellosis: The role of poultry meat. Clin. Microbiol. Infect. 2016, 22, 110–121. [Google Scholar] [CrossRef]
- Musa, L.; Proietti, P.C.; Marenzoni, M.L.; Stefanetti, V.; Kika, T.S.; Blasi, F.; Magistrali, C.F.; Toppi, V.; Ranucci, D.; Branciari, R.; et al. Susceptibility of Commensal E. coli Isolated from Conventional, Antibiotic-Free, and Organic Meat Chickens on Farms and at Slaughter toward Antimicrobials with Public Health Relevance. Antibiotics 2021, 10, 1321. [Google Scholar] [CrossRef]
- Jamshidi, A.; Zeinali, T. Significance and Characteristics of Listeria monocytogenes in Poultry Products. Int. J. Food Sci. 2019, 2019, 7835253. [Google Scholar] [CrossRef]
- Diarrassouba, F.; Diarra, M.S.; Bach, S.; Delaquis, P.; Pritchard, J.; Topp, E.; Skura, B.J. Antibiotic resistance and virulence genes in commensal Escherichia coli and Salmonella isolates from commercial broiler chicken farms. J. Food Prot. 2007, 70, 1316–1327. [Google Scholar] [CrossRef]
- Popa, S.A.; Morar, A.; Ban-Cucerzan, A.; Imre, K. Last decade mini-review of the scientific progresses in the monitoring of the occurrence and antimicrobial susceptibility profile of poultry origin Campylobacter spp. within the European Union countries. Rev. Rom. Med. Vet. 2022, 32, 75–82. [Google Scholar]
- Ștefan, G.; Predescu, C.; Bărăităreanu, S. Evaluation of growth potential of Listeria monocytogenes in meat products ready to eat. Rev. Rom. Med. Vet. 2024, 34, 129–132. [Google Scholar]
- Wagenaar, J.A.; Newell, D.G.; Kalupahana, R.S.; Mughini-Gras, L. Campylobacter: Animal reservoirs, human infections, and options for control. In Zoonoses: Infections Affecting Humans and Animals; Springer: Berlin/Heidelberg, Germany, 2023; pp. 267–293. [Google Scholar]
- Silva, J.; Leite, D.; Fernandes, M.; Mena, C.; Gibbs, P.A.; Teixeira, P. Campylobacter spp. as a foodborne pathogen: A review. Front. Microbiol. 2011, 2, 200. [Google Scholar] [CrossRef]
- Sala, C.; Morar, A.; Tîrziu, E.; Nichita, I.; Imre, M.; Imre, K. Environmental occurrence and antibiotic susceptibility profile of Listeria monocytogenes at a slaughterhouse raw processing plant in Romania. J. Food Prot. 2016, 79, 1794–1797. [Google Scholar] [CrossRef]
- Ciui, S.; Morar, A.; Tîrziu, E.; Herman, V.; Ban-Cucerzan, A.; Popa, S.A.; Morar, D.; Imre, M.; Olariu-Jurca, A.; Imre, K. Causes of Post-Mortem Carcass and Organ Condemnations and Economic Loss Assessment in a Cattle Slaughterhouse. Animals 2023, 13, 3339. [Google Scholar] [CrossRef]
- Skarp, C.P.A.; Hännien, M.L.; Rautelin, H.I.K. Campylobacteriosis: The role of poultry meat. Clin. Microbiol. Infect. 2016, 22, 103–109. [Google Scholar] [CrossRef]
- Stella, S.; Soncini, G.; Ziino, G.; Panebianco, A.; Pedonese, F.; Nuvoloni, R.; Di Giannatale, E.; Colavita, G.; Alberghini, L.; Giaccone, V. Prevalence and quantification of thermophilic Campylobacter spp. in Italian retail poultry meat: Analysis of influencing factors. Food Microbiol. 2017, 62, 232–238. [Google Scholar] [CrossRef]
- Popa, S.A.; Morar, A.; Ban-Cucerzan, A.; Tîrziu, E.; Herman, V.; Imre, M.; Florea, T.; Morar, D.; Pătrânjan, R.T.; Imre, K. First study on the frequency of isolation and phenotypic antimicrobial resistance profiles of pig- and cattle-origin Campylobacter strains in Romania. Vet. Res. Commun. 2024, 48, 2621–2627. [Google Scholar] [CrossRef]
- Mak, P.H.; Rehman, M.A.; Kiarie, E.G.; Topp, E.; Diarra, M.S. Production systems and important antimicrobial resistant-pathogenic bacteria in poultry: A review. J. Anim. Sci. Biotechnol. 2022, 13, 148. [Google Scholar] [CrossRef]
- World Health Organization. Global Antimicrobial Resistance and Use Surveillance System (GLASS) Report 2021; World Health Organization: Geneva, Switzerland, 2021; p. 180. [Google Scholar]
- Barata, R.; Saavedra, M.J.; Almeida, G. A Decade of Antimicrobial Resistance in Human and Animal Campylobacter spp. Isolates. Antibiotics 2024, 13, 904. [Google Scholar] [CrossRef]
- Myintzaw, P.; Jaiswal, A.K.; Jaiswal, S. A review on Campylobacteriosis associated with poultry meat consumption. Food Rev. Int. 2022, 39, 2107–2121. [Google Scholar] [CrossRef]
- ISO 10272-1; Microbiology of the Food Chain–Horizontal Method for Detection and Enumeration of Campylobacter spp.–Part 1: Detection Method. ISO (International Organization for Standardization): Geneva, Switzerland, 2017.
- Wang, G.; Clark, C.G.; Taylor, T.M.; Pucknell, C.; Barton, C.; Price, L.; Woodward, D.L.; Rodgers, F.G. Colony multiplex PCR assay for identification and differentiation of Campylobacter jejuni, C. coli, C. lari, C. upsaliensis, and C. fetus subsp. fetus. J. Clin. Microbiol. 2002, 40, 4744–4747. [Google Scholar] [CrossRef]
- Clinical and Laboratory Standards Institute (CLSI). Methods for Antimicrobial Dilution and Disk Susceptibility Testing of Infrequently Isolated or Fastidious Bacteria. CLSI Document M45, 3rd ed.; CLSI: Wayne, PA, USA, 2015. [Google Scholar]
- Karikari, A.B.; Obiri-Danso, K.; Frimpong, E.H.; Krogfelt, K.A. Antibiotic resistance of Campylobacter recovered from faeces and carcasses of healthy livestock. BioMed Res. Int. 2017, 2017, 4091856. [Google Scholar] [CrossRef]
- The European Committee on Antimicrobial Susceptibility Testing. Breakpoint Tables for Interpretation of MICs and Zone Diameters. Version 14.0, 2024. Available online: http://www.eucast.org (accessed on 10 May 2024).
- Amore, G.; Beloeil, P.-A.; Garcia Fierro, R.; Rizzi, V.; Stoicescu, A.-V. Manual for reporting 2024 antimicrobial resistance data under Directive 2003/99/EC and Commission Implementing Decision (EU) 2020/1729. EFSA Support. Publ. 2025, 22, 9238E. [Google Scholar] [CrossRef]
- Dan, S.; Tăbăran, A.; Mihaiu, L.; Mihaiu, M. Antibiotic susceptibility and prevalence of foodborne pathogens in poultry meat in Romania. J. Infect. Dev. Ctries. 2015, 9, 035–041. [Google Scholar]
- Tîrziu, E.; Bărbălan, G.; Morar, A.; Herman, V.; Cristina, R.T.; Imre, K. Occurrence and antimicrobial susceptibility profile of Salmonella spp. in raw and ready-to-eat foods and Campylobacter spp. in retail raw chicken meat in Transylvania, Romania. Foodborne Pathog. Dis. 2020, 17, 479–484. [Google Scholar] [CrossRef]
- Hue, O.; Le Bouquin, S.; Laisney, M.-J.; Allain, V.; Lalande, F.; Petetin, I.; Rouxel, S.; Quesne, S.; Gloaguen, P.-Y.; Picherot, M.; et al. Prevalence of and risk factors for Campylobacter spp. contamination of broiler chicken carcasses at the slaughterhouse. Food Microbiol. 2010, 27, 992–999. [Google Scholar] [CrossRef]
- Perez-Arnedo, I.; Gonzalez-Fandos, E. Prevalence of Campylobacter spp. in Poultry in Three Spanish Farms, A Slaughterhouse and A Further Processing Plant. Foods 2019, 8, 111. [Google Scholar] [CrossRef]
- Berrang, M.E.; Buhr, R.J.; Cason, J.A.; Dickens, J.A. Broiler Carcass Contamination with Campylobacter from Feces during Defeathering. J. Food Prot. 2001, 64, 2063–2066. [Google Scholar] [CrossRef]
- Kovačić, A.; Listeš, I.; Vučica, C.; Kozačinski, L.; Tripković, I.; Siško-Kraljević, K. Distribution and genotypic characterization of Campylobacter jejuni isolated from poultry in Split and Dalmatia County, Croatia. Zoonoses Public Health 2013, 60, 269–276. [Google Scholar] [CrossRef]
- Mäesaar, M.; Kramarenko, T.; Meremäe, K.; Sõgel, J.; Lillenberg, M.; Häkkinen, L.; Ivanova, M.; Kovalenko, K.; Hörman, A.; Hänninen, M. Antimicrobial Resistance Profiles of Campylobacter spp. Isolated from Broiler Chicken Meat of Estonian, Latvian and Lithuanian Origin at Estonian Retail Level and from Patients with Severe Enteric Infections in Estonia. Zoonoses Public Health 2016, 63, 89–96. [Google Scholar] [CrossRef]
- Szosland-Fałtyn, A.N.N.A.; Bartodziejska, B.; Krolasik, J.; Paziak-Domańska, B.E.A.T.A.; Korsak, D.; Chmiela, M. The Prevalence of Campylobacter spp. in polish poultry meat. Pol. J. Microbiol. 2018, 67, 117–120. [Google Scholar]
- Guyard-Nicodème, M.; Rivoal, K.; Houard, E.; Rose, V.; Quesne, S.; Mourand, G.; Rouxel, S.; Kempf, I.; Guillier, L.; Gauchard, F.; et al. Prevalence and characterization of Campylobacter jejuni from chicken meat sold in French retail outlets. Int. J. Food Microbiol. 2015, 203, 8–14. [Google Scholar] [CrossRef] [PubMed]
- Natsos, G.; Mouttotou, N.K.; Magiorkinis, E.; Ioannidis, A.; Rodi-Burriel, A.; Chatzipanagiotou, S.; Koutoulis, K.C. Prevalence of and risk factors for Campylobacter spp. colonization of broiler chicken flocks in Greece. Foodborne Pathog. Dis. 2020, 17, 679–686. [Google Scholar] [CrossRef] [PubMed]
- Madden, R.H.; Moran, L.; Scates, P.; McBride, J.; Kelly, C. Prevalence of Campylobacter and Salmonella in Raw Chicken on Retail Sale in the Republic of Ireland. J. Food Prot. 2011, 74, 1912–1916. [Google Scholar] [CrossRef] [PubMed]
- Abdel-Naeem, H.H.; Ebaid, E.M.; Khalel, K.H.; Imre, K.; Morar, A.; Herman, V.; El-Nawawi, F.A. Decontamination of chicken meat using dielectric barrier discharge cold plasma technology: The effect on microbial quality, physicochemical properties, topographical structure, and sensory attributes. LWT 2022, 165, 113739. [Google Scholar] [CrossRef]
- Nobile, C.G.A.; Costantino, R.; Bianco, A.; Pileggi, C.; Pavia, M. Prevalence and Pattern of Antibiotic Resistance of Campylobacter spp. in Poultry Meat in Southern Italy. Food Control 2013, 32, 715–718. [Google Scholar] [CrossRef]
- Hull, D.M.; Harrell, E.; van Vliet, A.H.M.; Correa, M.; Thakur, S. Antimicrobial resistance and interspecies gene transfer in Campylobacter coli and Campylobacter jejuni isolated from food animals, poultry processing, and retail meat in North Carolina, 2018–2019. PLoS ONE 2021, 16, e0246571. [Google Scholar] [CrossRef]
- Poudel, S.; Li, T.; Chen, S.; Zhang, X.; Cheng, W.-H.; Sukumaran, A.T.; Kiess, A.S.; Zhang, L. Prevalence, Antimicrobial Resistance, and Molecular Characterization of Campylobacter Isolated from Broilers and Broiler Meat Raised without Antibiotics. Microbiol. Spectr. 2022, 10, e00251-22. [Google Scholar] [CrossRef]
- Wei, B.; Cha, S.Y.; Yoon, R.H.; Kang, M.; Roh, J.H.; Seo, H.S.; Lee, J.A.; Jang, H.K. Prevalence and antimicrobial resistance of Campylobacter spp. isolated from retail chicken and duck meat in South Korea. Food Control 2016, 62, 63–68. [Google Scholar] [CrossRef]
- Rivera-Mendoza, D.; Martínez-Flores, I.; Santamaría, R.I.; Lozano, L.; Bustamante, V.H.; Pérez-Morales, D. Genomic Analysis Reveals the Genetic Determinants Associated with Antibiotic Resistance in the Zoonotic Pathogen Campylobacter spp. Distributed Globally. Front. Microbiol. 2020, 11, 513070. [Google Scholar] [CrossRef]
- Ma, L.; Konkel, M.E.; Lu, X. Antimicrobial Resistance Gene Transfer from Campylobacter jejuni in Mono-and Dual-Species Biofilms. Appl. Environ. Microbiol. 2021, 87, e00659-21. [Google Scholar] [CrossRef]
- Yao, H.; Shen, Z.; Wang, Y.; Deng, F.; Liu, D.; Naren, G.; Dai, L.; Su, C.-C.; Wang, B.; Wang, S.; et al. Emergence of a Potent Multidrug Efflux Pump Variant That Enhances Campylobacter Resistance to Multiple Antibiotics. mBio 2016, 7, e01543-16. [Google Scholar] [CrossRef]
- Davin-Regli, A.; Pages, J.-M.; Ferrand, A. Clinical Status of Efflux Resistance Mechanisms in Gram-Negative Bacteria. Antibiotics 2021, 10, 1117. [Google Scholar] [CrossRef]
- Baltoiu, M.; Gradisteanu Pircalabioru, G.; Cristea, D.; Sorokin, M.; Dragomirescu, C.C.; Stoica, I. Genetic Diversity, Virulence, and Antibiotic Resistance Determinants of Campylobacter jejuni Isolates in Romania. Pathogens 2024, 13, 716. [Google Scholar] [CrossRef]
| Origin | Type of Samples | Number of Samples | Number of Positive Samples | Prevalence, % [95% CI] |
|---|---|---|---|---|
| Slaughterhouse | Neck skin | 40 | 13 | 32.5% [20.1–48.0] |
| Retail | Fillets | 30 | 7 | 23.3% [11.8–40.9] |
| Backs | 30 | 5 | 16.7% [7.3–33.6] | |
| Necks | 30 | 11 | 36.7% [21.9–54.5] | |
| Total | - | 130 | 36 | 27.7% |
| Antimicrobials | S (%) | I (%) | R (%) |
|---|---|---|---|
| Ciprofloxacin | 18 (50.0%) | 3 (8.4%) | 15 (41.6%) |
| Chloramphenicol | 30 (83.4%) | 0 (0.0%) | 6 (16.6%) |
| Erythromycin | 34 (94.4%) | 1 (2.8%) | 1 (2.8%) |
| Ertapenem | 34 (94.4%) | 0 (0.0%) | 2 (5.6%) |
| Gentamicin | 32 (88.9%) | 0 (0.0%) | 4 (11.1%) |
| Tetracycline | 23 (63.9%) | 4 (11.1%) | 9 (25.0%) |
| Resistance Category | Antimicrobial Resistance Profile | Number of Isolates | Classes with Resistance |
|---|---|---|---|
| Against two | CIP + TET | 4 | fluoroquinolones, tetracyclines |
| GEN + TET | 2 | aminoglycosides, tetracyclines | |
| Against three | CIP + CHL + TET | 2 | fluoroquinolones, amphenicols, tetracyclines |
| Against four | CIP + CHL + TET + GEN | 1 | fluoroquinolones, amphenicols, tetracyclines, aminoglycosides |
Disclaimer/Publisher’s Note: The statements, opinions and data contained in all publications are solely those of the individual author(s) and contributor(s) and not of MDPI and/or the editor(s). MDPI and/or the editor(s) disclaim responsibility for any injury to people or property resulting from any ideas, methods, instructions or products referred to in the content. |
© 2025 by the authors. Licensee MDPI, Basel, Switzerland. This article is an open access article distributed under the terms and conditions of the Creative Commons Attribution (CC BY) license (https://creativecommons.org/licenses/by/4.0/).
Share and Cite
Popa, S.A.; Herman, V.; Tîrziu, E.; Morar, A.; Ban-Cucerzan, A.; Imre, M.; Pătrînjan, R.-T.; Imre, K. Public Health Risk of Campylobacter spp. Isolated from Slaughterhouse and Retail Poultry Meat: Prevalence and Antimicrobial Resistance Profiles. Pathogens 2025, 14, 316. https://doi.org/10.3390/pathogens14040316
Popa SA, Herman V, Tîrziu E, Morar A, Ban-Cucerzan A, Imre M, Pătrînjan R-T, Imre K. Public Health Risk of Campylobacter spp. Isolated from Slaughterhouse and Retail Poultry Meat: Prevalence and Antimicrobial Resistance Profiles. Pathogens. 2025; 14(4):316. https://doi.org/10.3390/pathogens14040316
Chicago/Turabian StylePopa, Sebastian Alexandru, Viorel Herman, Emil Tîrziu, Adriana Morar, Alexandra Ban-Cucerzan, Mirela Imre, Răzvan-Tudor Pătrînjan, and Kálmán Imre. 2025. "Public Health Risk of Campylobacter spp. Isolated from Slaughterhouse and Retail Poultry Meat: Prevalence and Antimicrobial Resistance Profiles" Pathogens 14, no. 4: 316. https://doi.org/10.3390/pathogens14040316
APA StylePopa, S. A., Herman, V., Tîrziu, E., Morar, A., Ban-Cucerzan, A., Imre, M., Pătrînjan, R.-T., & Imre, K. (2025). Public Health Risk of Campylobacter spp. Isolated from Slaughterhouse and Retail Poultry Meat: Prevalence and Antimicrobial Resistance Profiles. Pathogens, 14(4), 316. https://doi.org/10.3390/pathogens14040316














